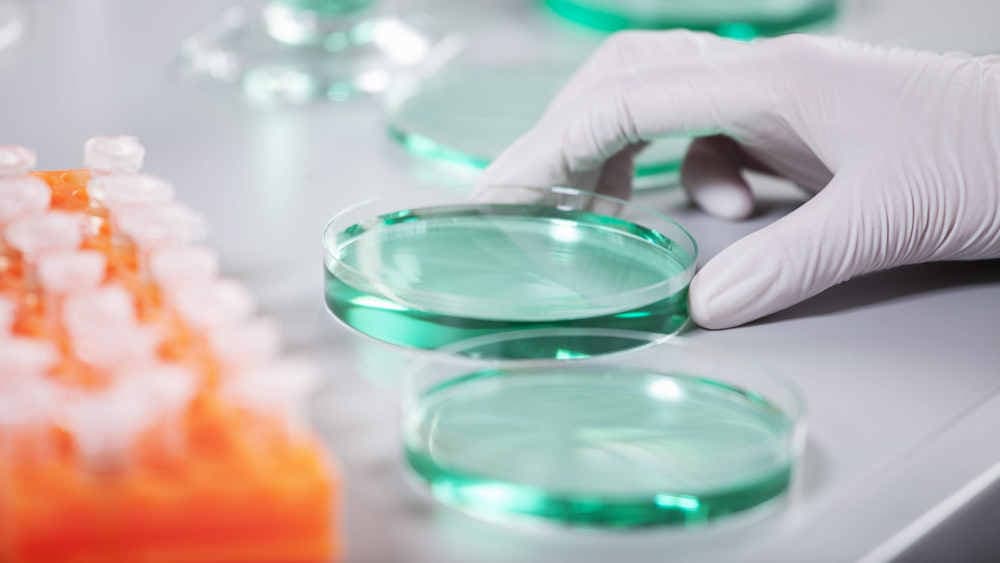
Fachverband für mehr geschlechtssensible Forschung

Die Deutsche Gesellschaft für Innere Medizin (DGIM) hat die dringende Notwendigkeit von mehr medizinischer Forschung angemahnt, die Unterschiede zwischen Frauen und Männern berücksichtigt. „Bei der geschlechtssensiblen Ausrichtung der Medizin stehen wir in der Forschung in vielen Bereichen noch am Anfang“, sagte Dagmar Führer-Sakel, Präsidentin der DGIM, der Düsseldorfer Rheinischen Post. „Dies gilt insbesondere für hormonelle und molekulare Grundlagen - hier bewegen wir uns gewissermaßen noch im Mittelalter.“
Warum geschlechtssensible Medizin für Frauengesundheit wichtig ist
Grund dafür sei auch die Studienlage, erläuterte Führer-Sakel. „Studien werden überwiegend an männlichen Probanden durchgeführt.“ Die daraus gewonnenen Ergebnisse würden anschließend häufig ohne weitere Differenzierung auf den weiblichen Organismus übertragen. Sowohl Forschungsministerin Dorothee Bär (CSU) als auch Gesundheitsministerin Nina Warken (CDU) hatten eine Förderung von mehr Forschung zur Frauengesundheit angekündigt. Konkrete Pläne stehen aber noch aus.